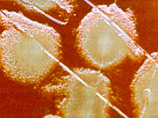

|
 |
 |
 |
| ||||||||||||
 |
Вокруг света
Половина мясных продуктов на прилавках США заражена стафилококком
9:59AM Saturday, Apr 16, 2011
Половина мясных продуктов в супермаркетах США заражена стафилококком. К такому выводу пришли эксперты Транснационального института исследования геномики Аризоны. Они проанализировали биологический состав говядины, курятины, свинины и индейки, купленных в продовольственных магазинах Чикаго (штат Иллинойс), Лос-Анджелеса (штат Калифорния), Вашингтона, Флэгстаффа (штат Аризона) и Форт-Лодердэйла (штат Флорида). "Проведенные нами тесты свидетельствуют, что большое количество мяса и птицы в нашей стране заражено бактериями стафилококка с устойчивостью к лекарствам", - заявил один из авторов исследования Пол Кайм. По его словам, несмотря на малое количество взятых проб, географический охват исследования, а также тот факт, что оно проводилось как в крупных, так и в малых городах, указывает на его объективность. "Теперь нам необходимо выяснить, насколько большой риск это представляет для потребителей", - добавил Кайм. Бактерии стафилококка встречаются у 25 процентов здоровых людей, сообщает ИТАР-ТАСС. Это, по мнению экспертов аризонского института, указывает на недостаточную стерильность на американских фермах и продовольственных предприятиях. Согласно данным исследования, детали которого будут опубликованы в журнале "Клинические инфекционные заболевания", в 2 процента протестированных упаковок мяса была обнаружен устойчивый к антибиотикам метициллинрезистентный стафилококк. Заражение этой бактерией может привести к трудноизлечимым заболеваниям, в том числе пневмонии и анемии. По мнению экспертов, появление метициллинрезистентного стафилококка в мясе объясняется распространенной в США практикой добавления антибиотиков в корм животных. Это могло привести к появлению у бактерий устойчивости к лекарственным препаратам.
|  |